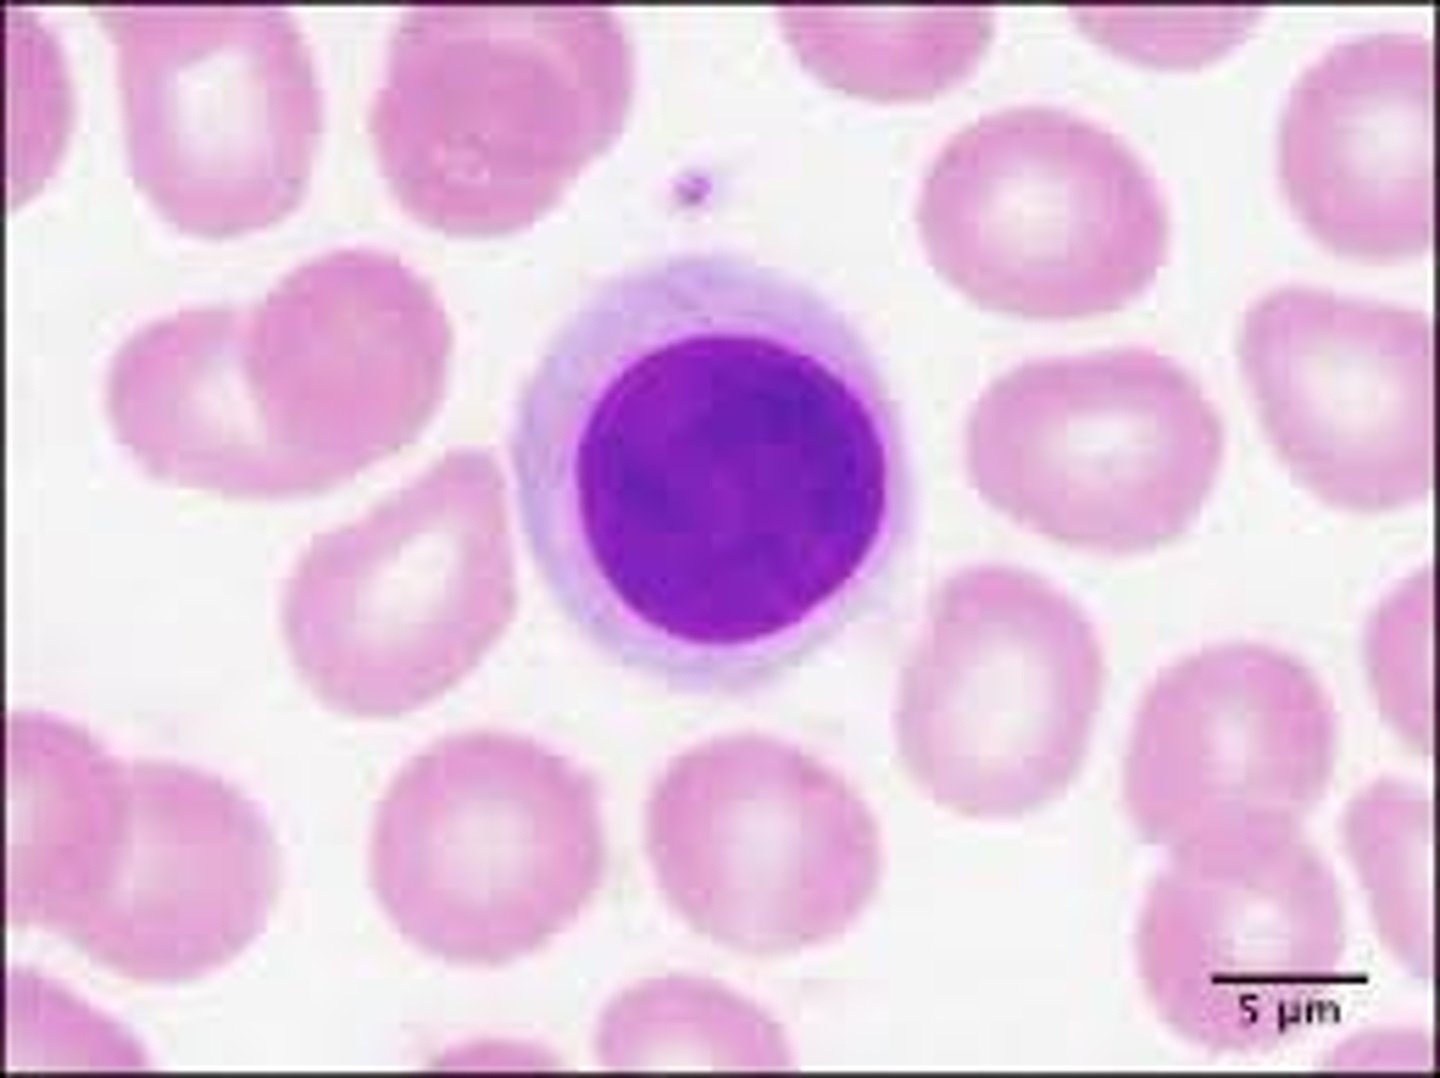
<p>Hvis en B celle modtager nok aktiveringssignaler, så kan den udvikle sig til en plasmacelle, som kan secernere frie antistof molekyler.</p><p>De har mere cytoplasma og kerneforhold end en hvilende B celle.</p>

1/24
Looks like no tags are added yet.
Name | Mastery | Learn | Test | Matching | Spaced | Call with Kai |
|---|
No analytics yet
Send a link to your students to track their progress
Hvor finder man det største reservoir af B celler i kroppen?
I de sekundære lymfoide organer
Hvad er B cellernes overordnede funktioner i immunsystemet?
1. Producere antistoffer og differentiere til plasmaceller
2. Effektive APC'er
3. Danner en lang række cytokiner
Er BCR signaltransducerende?
Nej, den kræver molekyle komplekset CD79a/CD79b for at kunne sende signal
Hvad består ko receptoren af, som øger folsomheden over for antigen stimulering?
CD19
CD21
CD81
Hvad er de vigtigste overflade markører for B celler?
CD19
CD20
Beskriv B-1 celler
De befinder sig i bughulen og pleurarum.
De fornyr sig selv gennem celleproliferation.
De menes at være kilden til de naturlige antistoffer der produceres spontant uden antigenstimulation.
De regnes for at høre under det innate immunsystem.
Beskriv B-2 celler
Det er den almindelige pulje af B celler.
De fornys gennem knoglemarven.
Beskriv en plasmacelle
Hvis en B celle modtager nok aktiveringssignaler, så kan den udvikle sig til en plasmacelle, som kan secernere frie antistof molekyler.
De har mere cytoplasma og kerneforhold end en hvilende B celle.
Beskriv overordnet trinnene i interaktionen mellem B og T celle
Signal 1: Binding af antigen til BCR
Antigenpræsentation til Th celler
Signal 2: Kostimulering- engagement af CD40
Signal 3: Cytokiner dirigerer immunglobulin klasseskift og proliferation
Beskriv signal 1: Binding af antigen til BCR
1. BCR består af membran bundne immunglobuliner der sidder på B lymfocyttens overflade.
2. Signal 1 kommer når BCR bliver krydsbundet
3. BCR kan ikke sende signal, men dette sendes gennem CD79a og CD79b
4. Er antigenet dækket af komplement faktorer, så forstærkes signal 1, da fragmenterne binder til B cellens koreceptorer (CD19, 21 eller 81)
5. Signal 1 igangsætter optagelse af antigen og opregulering af CD80 og CD86

Hvad sker der hvis B cellerne kun får signal 1?
Får naive B celler kun signal 1, vil de blive anergiske og undergå apoptose.
Får B cellen også signal 2, så aktiveres den.

Beskriv signal 2: Kostimulering, engagement af CD40
Signal 2 forekommer som et respons på Th cellens egen aktivering.
Hermed opregulerer Th cellen CD40/CD40L interaktion.
CD40L fra Th cellen reagere med CD40 fra B cellens overflade.

Hvorfor er signal 2, kostimulering og engagement af CD40 så vigtigt?
Det er essentielt for at B cellen kan undergå immunglobulin klasseskift.
Det er også vigtigt for dannelsen af kimcentre i de sekundære lymfoide organer.

Beskriv signal 3: Cytokiner dirigerer immunglobulin klasseskift og proliferation
1. Når B cellen har modtaget signal 1 og 2, så udtrykker cellen cytokinreceptorer på sin overflade.
2. Det er cytokinmiljøet som B cellen udsættes fra, i høj grad fra den aktiverede Th celle, der bestemmer hvilken immunglobulin klasse at B cellen begynder og secernere.

Hvad sker der med B cellen når den er blevet fuldt ud aktiveret?
Så vil den differentiere til en plasmacelle, der secernere enorme mængder antistoffer.
Beskriv affinitetsmodning for B celler
Det er en proces der finder sted i det adaptive immunrespons hvor antistoffernes bindingsstyrke over for et antigen øges ved gentagen eksponering over for samme antigen.
Dette er med til at sikre at immunforsvaret bliver mere effektivt i bekæmpelsen af patogener ved gentagne infektioner.
Hvordan er somatisk hypermutation involveret i affinitetsmodningen af antistoffer?
Der forekommer hyppige mutationer i de genområder der koder for antistoffernes antigenbindende områder.
Somatisk hypermutation finder kun sted i B celler og IKKE T celler.
Hvorfor undergår immunglobuliner immunglobulin klasseskift?
Immunglobulin klasseskift gør det muligt for B cellen at skift den type antistof som de producerer fra en klasse, til en anden.
Det er afgørende for at tilpasse immunforsvaret til forskellige typer af patogener og infektionssteder.
Processen er meget afhængig af Th celler.
Beskriv overordnet de forskellige trin en B celle skal igennem for at kunne undergå immunglobulin klasseskift:
Signal 1: Antigenbinding til BCR
Antigenpræsentation og T celle interaktion
Signal 2: Kostimulering- engagement af CD40
Signal 3: Cytokiner dirigerer immunglobulinklasseskift, proliferation og differentiering
Beskriv signal 1: Antigenbinding ved immunglobulin klasseskift:
Når B cellen møder sit specifikke antigen, så krydsbindes BCR, og der sendes signal ind gennem BCR, gennem de signaltransducerende molekyler CD79a og CD79b
Beskriv 'antigenpræsentation og T celle interaktion' ved immunglobulin klasseskift:
Efter internalisering nedbrydes antigenet delvist og peptider derfra præsenteres på B cellens overflade- bundet til MHC II.
En Th celle der er specifik for det præsenterende MHC II peptidkompleks vil interagere med B cellen og danne en immunologisk synapse.
Beskriv signal 2: Kostimulering og engagement af CD40 ved immunglobulin klasseskift:
Th cellen opregulerer CD40/CD40L efter aktivering.
Signalet er afgørende for at B cellen kan udføre sine immunglobulin klasseskift.
B cellen som indtil nu kun har dannet IgM og IgD, udvikler sig til en plasmacelle der kan danne IgG, IgA og IgE
Beskriv signal 3: Cytokiner dirigerer immunglobulinklasseskift, prolferation og differentieren, ved immunglobulin klasseskift:
Efter B cellen modtager signal 1 og 2 vil den udtrykke cytokin receptorer.
Det er cytokinmiljøet der påvirker hvilken immunglobulinklasse der vil blive dannet når den differentierer til en plasmacelle.
IL-4 og IL-13 fremmer produktionen af IgE
TGF-B fremmer produktionen af IgA
Cytokinerne sitmulerer B cellen til voldsom proliferation
Beskriv det primære antistofsvar
1. Følger en enkelt eksponering for et antigen
2. Viser sig med en initial latensperiode på ca. 3-4 dage, hvor antistoffer endnu ikke kan påvises.
3. Produktionen af antistoffer stiger derefter eksponentielt, typisk nående et maksimalt niveau efter 1-2 uger, før den aftager.
4. Karakteristisk er, at IgM er den først producerede immunglobulinklasse, der hurtigst når sin plateaufase og derefter gradvist afløses af IgG som den dominerende klasse i de senere faser af det primære respons.

Beskriv det sekundære antistofsvar
1. Latenstiden er stort set forsvundet, og en stigning i antistofproduktionen kan konstateres allerede efter et døgns forløb.
2. De opnåede antistofkoncentrationer er langt højere.
3. Antistofsvarets varighed er længere, da produktionen klinger langsommere af.
4. Immunoglobulinklassesammensætningen er ændret: IgG produceres lige så tidligt som IgM, men langt mere IgG end IgM produceres generelt i det sekundære svar.
